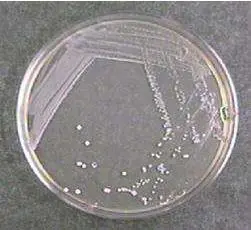
四区平板划线

平板接种步骤学习(平板划线、平板倾注、平板涂布)
发布时间:2026-01-05 浏览次数:4760
平板划线
平板划线的操作是为了将菌稀释从而获得纯培养的单菌落。划线有多种方式。
1.三区平板划线。
三区划线中第一区所占的区域大约是平板面积的五分之一到四分之一。第二区搭过第一区的面积使微生物数量得到“稀释”,第三区搭过第二区的面积使微生物数量进一步“稀释”,第三区不可与第一区有重叠的划线。一般适用于可疑菌落的分离,或可疑菌落的二次平板分离。通常划完三区后就可以出现单菌落。三区划线如下图。

2.四区平板划线。
四区平板划线与上面的三区划线类似,只是每一区的划线面积相应减小,同样第三区不可与第一区相重叠,第四区不可与第二区和第一区相重叠,四区划线比三区划线多稀释一次,这样通过增加划线区域,有可能会分离到更多更纯的单菌落。
3.单次连续“之”字平板划线
其实在微生物划线接种中,无论是试管斜面划线接种还是平板划线接种,都会用到“之”字划线。“之”字划线的要领是:往复不间断划线,但是又不与划过的路线重复或重叠。如果菌量比较大,就可以划得更为密集或者增加一块平板继续“之”字划线(即连续划两块板)。“之”字划线一般适用于分离本身在此培养基上单一且黏性较大的菌类或可疑菌落的纯培养。操作如下图所示。

4.网状平板划线
网状平板花线,其实就是两次方向垂直的“之”字划线重叠在一起,一般用于纯培养,目的是通过增加更多的划线路径来获得更多的纯培养物,特别是针对一些生长较慢或菌落非常细小的菌类。
在以上的这些平板划线的方式中,三区平板划线最常用的是分区划线法,详细操作步骤见下图。

① 将接种环放在火焰上灼烧,直到接种还环烧红。
② 在火焰旁冷却接种换环,打开试管塞。
③ 将试管口通过火焰,旋转试管口并小幅度来回移动试管,切不可长时间让试管口停滞于火焰上加热。
④ 将已冷却的接种环伸入菌液中,挑取一环菌液。
⑤ 将试管口通过火焰几次后,塞上试管塞。将试管放回试管架。
⑥ 左手拿起培养皿,将培养皿盖打开一条缝隙,右手将沾有菌液的接种环迅速深入平皿内。从平皿边缘开始“之”字划线(基准线也称第一区域),大约划过平皿的五分之一到四分之一左右的面积。关闭培养皿盖,将培养皿调转大约120°。再次灼烧接种环,将接种环在空气中或靠在培养皿盖内侧冷却后从第一区域末端开始往第二区内划线。两个区域划线的交角大约是120°。重复以上动作,完成第三区(甚至第四区)划线操作。注意:当前操作的划线只能与相邻前一区域相交,绝不能与其他区域的划线有重叠。
一般三区划线就能分离出单菌落,理想的三区分区划线平板培养后的结果见下图。第一区和第二区前部的细菌生长成“直线”,第二区后部的细菌生长呈“虚线”。第三区呈“虚线”和离散的“小点”(即单菌落)。

平板倾注
平板倾注接种的步骤具体操作如图。

1. 先在酒精灯火焰旁打开无菌空平皿,注意开启幅度不宜过大,加入一定量的样液。
2. 按“倒平板”的步骤加入培养基(注意培养基要水浴保温在46°左右,温度太低,培养基容易凝固,温度太高容易烫伤细菌)。
3. 将平皿盖上盖。在桌面划圆圈滑动,幅度不要太大以免培养基洒漏或溅到平皿皿盖。混合均匀后,将平皿置于桌面,待平皿凝固后,翻转平皿堆叠放于培养箱中培养。有时还会在凝固的培养基表面再倒一层培养基,防止蔓延菌落的出现。
平板涂布
平板涂布是将少量(通常0.2mL~0.5mL)系列稀释的菌液涂布在预先倾注好的固体培养基上,靠涂布棒在琼脂表面均匀铺开,培养后获得菌落个数的一种计数技术。平板涂布的操作如图。

1. 无菌移取一定量样液于平皿固体培养基中央。
2. 玻璃涂布棒蘸取酒精。注意始终保持涂布棒的涂布一端向下,并且涂布棒上的酒精既要覆盖全部即将深入平皿的部位又不能滴淌。
3. 通过酒精灯火焰点燃。一定注意防止酒精倒流或溅溢引燃物品或烧到手。
4. 左手将皿盖在酒精灯火焰旁边打开一个缝隙,右手将灼烧过的涂布棒涂布一端靠在皿盖上冷却。冷却后将平皿盖开大一些,用涂布棒刮样液在培养基表面均匀涂布开。涂布的时候,涂布棒不能触碰平皿内侧边缘。如果有条件,涂布过程应将平皿置于旋转的涂布台上。
5. 涂布棒再次蘸取酒精,通过火焰点燃灭菌。
6. 待平皿表面液体晾干后,翻转平皿,置于培养箱培养。
来源:网络转载。
说明:文章、视频、图片等所有内容,仅用于学习交流,若有侵权内容及其他涉法内容,请及时联系删除或修改,特此声明!

